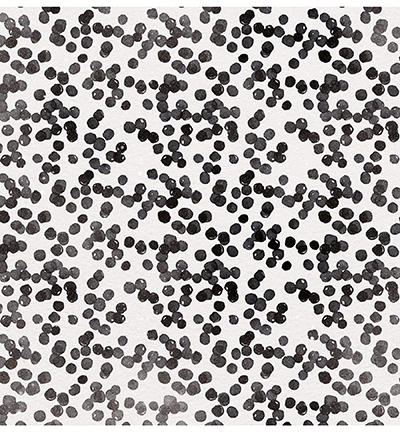
SCRAPUS74 - StudioLight - Scrap Double face, Ultimate Scrap Collection nr.74 - Scrap - Detail 1

Scrap Double face, Ultimate Scrap Collection nr.74
Taille / Contenu: 30,4x30,4cm / 200 gr.
Fin de stock
€ 0,50 -43%
incl. 20.00% TVA
Disponible immédiatement
Ce bloc papier design StudioLight Scrap 200 gr. Dubbelzijdig, 304 x 304 mm, Ultimate Scrap Collection nr.74 contient des feuilles imprimées pour fonds, superpositions et panneaux décoratifs. Les motifs et couleurs sont coordonnés.
Utilisez le papier pour la carterie, le scrapbooking, le journaling ou le mixed media. Associez les feuilles à des tampons, matrices, stickers ou éléments prédécoupés dans le même style.